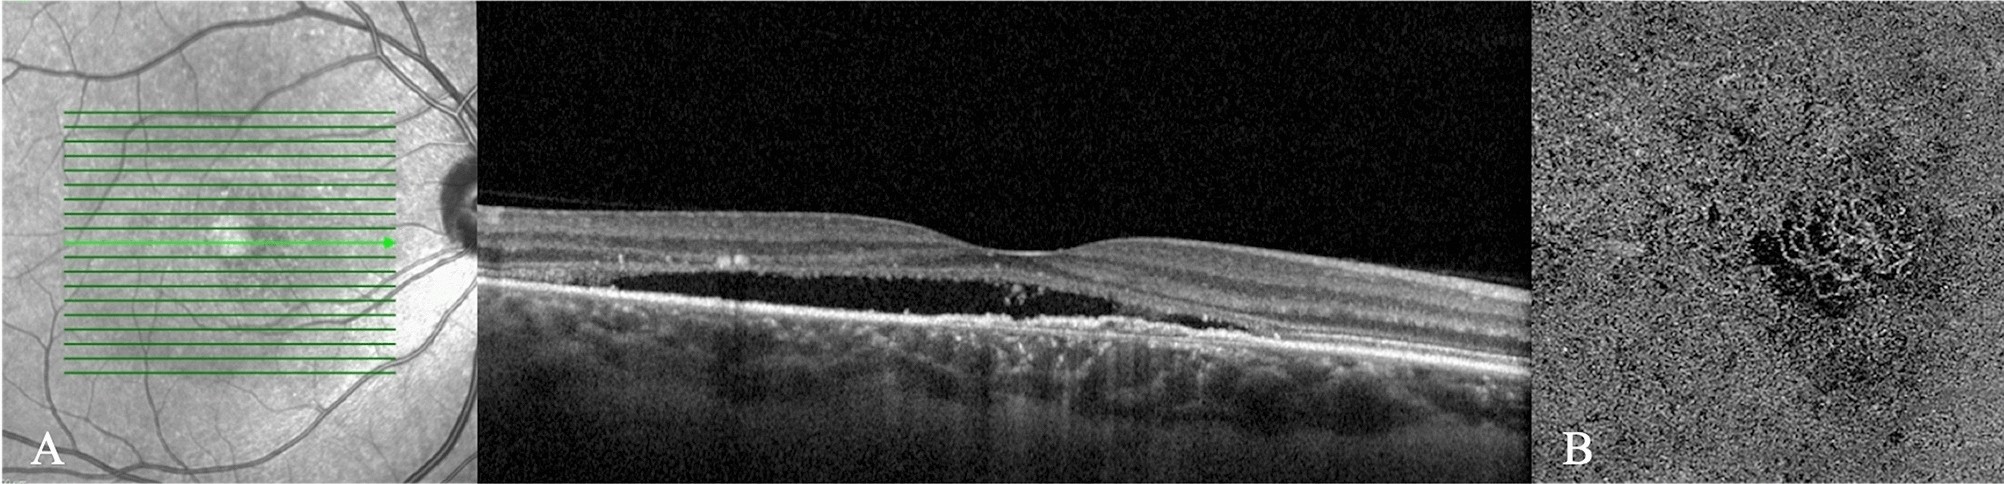
Figure 2

Figure 2
(A) Enhanced-depth imaging optical coherence tomography reveals dilated Haller’s layer vessels and attenuation of the choriocapillaris, and a flat irregular pigment epithelium detachment (FIPED) associated with subretinal fluid (SRF) and subretinal hyperreflective foci. (B) The enface OCT angiography demonstrates a neovascular lesion with tangled filamentous pattern within the FIPED.